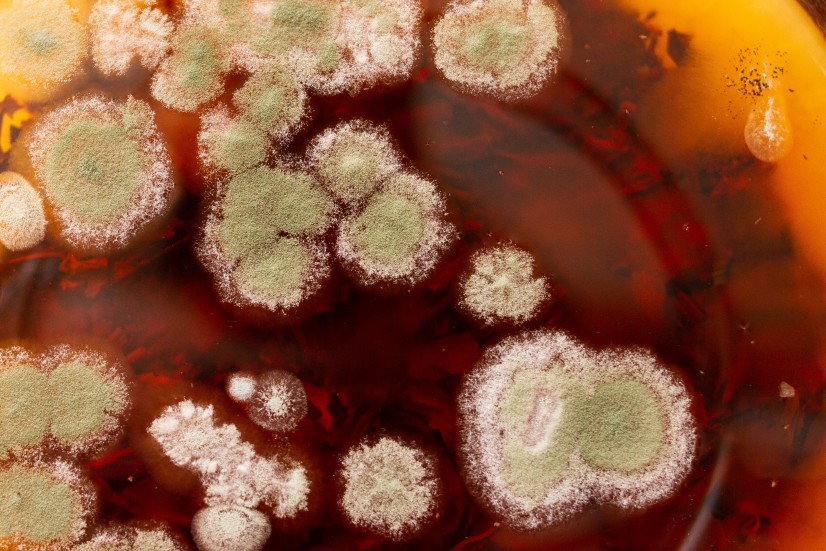

Les moisissures sont des champignons que l’on peut trouver aussi bien à l’intérieur qu’à l’extérieur. L’intoxication par les moisissures peut avoir des effets dangereux sur votre santé, c’est pourquoi un test peut être effectué pour détecter la présence de spores de moisissures, ainsi que l’étendue de l’infestation par les moisissures, afin que vous puissiez prendre les mesures correctives appropriées. Cet article fournit des informations sur les différentes façons de tester une infestation
Il s’agit d’une infestation de moisissures à l’intérieur de la maison.
L’infestation de moisissures à l’intérieur de la maison est un problème courant dans les régions pluvieuses. En outre, les maisons qui sont inondées ou gorgées d’eau en raison de problèmes de drainage, sont également à haut risque d’avoir des infestations de moisissures. La variété de moisissure noire toxique appelée Stachybotrys chartarum ou S. atra est dangereuse pour la santé humaine. L’infestation commence par la formation de moisissures sous les tapis, derrière les papiers peints et à l’intérieur de l’isolation, et elle se propage rapidement au reste de la maison. Si la croissance n’est pas contrôlée à temps, elle peut avoir des effets néfastes sur les intérieurs. En outre, votre propre santé peut être gravement affectée. Afin d’empêcher la croissance, des mesures doivent être prises pour inverser les effets. Il existe certains tests qui peuvent aider à la détection précoce de la croissance.
Procédures de test
La présence de moisissure est souvent détectée par son odeur caractéristique de moisi dans les endroits sombres et humides de la maison. Il se nourrit de matières organiques et se développe rapidement. Ce champignon n’est souvent pas visible à l’œil nu. Cependant, vous pouvez vous fier à l’odeur comme test de sa présence. Sinon, vous pouvez également vous appuyer sur les tests ci-dessous pour la détection :
Tests de surface
Si vous suspectez une possibilité de développement de ce champignon à l’intérieur de votre maison, vous pouvez tester la surface. Les surfaces possibles où il est susceptible de se développer sont sous le tapis, derrière les cloisons sèches, le papier peint, à l’intérieur de l’isolation, sur les armoires de cuisine près de l’évier, ou d’autres zones humides et sombres comme le sous-sol. Des kits de test de surface sont également disponibles sur le marché. Tout ce que vous avez à faire est de gratter la surface avec un coton-tige, puis de le tremper dans une solution chimique (incluse dans le kit). La solution change de couleur, si la moisissure est présente. C’est un bon moyen de tester les moisissures invisibles, avant qu’elles ne se développent suffisamment pour être repérées à l’œil nu.
Test de l’air
Vous pouvez sûrement compter sur vos sens olfactifs pour détecter la présence des champignons dans l’air. Cependant, il arrive souvent que la quantité ne soit pas suffisante pour dégager une odeur typique. Dans ce cas, vous pouvez tester l’air pour vérifier si des spores de champignons sont présentes. Vous pouvez choisir l’un des kits d’analyse de l’air disponibles sur le marché. Ces kits sont disponibles dans différentes gammes de prix. Ainsi, dans le cas où vous prévoyez de tester toute la maison, vous pourriez vouloir investir dans un produit plus économique.
Tests sanguins
Le syndrome toxique des moisissures est un état de santé grave caractérisé par une variété de symptômes tels que saignements de nez, maux de gorge, écoulement nasal, douleurs abdominales, fièvre, troubles de la personnalité, engourdissements, vertiges, etc. Les symptômes de l’intoxication ne sont pas spécifiques à cette seule condition, d’où un retard fréquent dans le diagnostic. Les symptômes de l’intoxication ne sont pas spécifiques à cette seule affection, d’où le retard souvent pris dans le diagnostic. En général, les gens sont malades mais ne parviennent jamais à trouver la cause dans ce champignon. En outre, les médecins peuvent également ne pas faire le lien avec ces symptômes. Cependant, la moisissure noire affecte l’encapsulation des nerfs appelée myéline, ce qui peut s’avérer préjudiciable à la santé d’une personne
Il faut savoir que la moisissure noire est une maladie qui touche les nerfs.
Un test sanguin permet de détecter la possibilité de l’exposition à ce champignon. La présence d’anticorps tels que les IgE et IgG, peut vérifier la possibilité de l’exposition. Cependant, ils ne sont pas suffisants pour indiquer le niveau d’intoxication. Dans ce cas, il peut être nécessaire de tester les niveaux de biotoxines présents dans votre organisme. Une quantité plus importante de biotoxines indique une plus grande exposition aux moisissures. Les tests sanguins n’étant pas courants, tous les laboratoires ne les pratiquent pas. En outre, l’assurance ne prévoit pas de couverture pour ces tests. Un traitement approprié peut être suggéré pour surmonter le problème.
Si un test d’intoxication aux moisissures se révèle négatif mais que vous soupçonnez toujours une infestation, vous pouvez appeler un professionnel pour diagnostiquer le problème. Cela devrait vous aider à éradiquer les champignons avant qu’ils ne se manifestent en un problème plus important
Il s’agit d’un problème de santé publique.

COMMENTAIRES